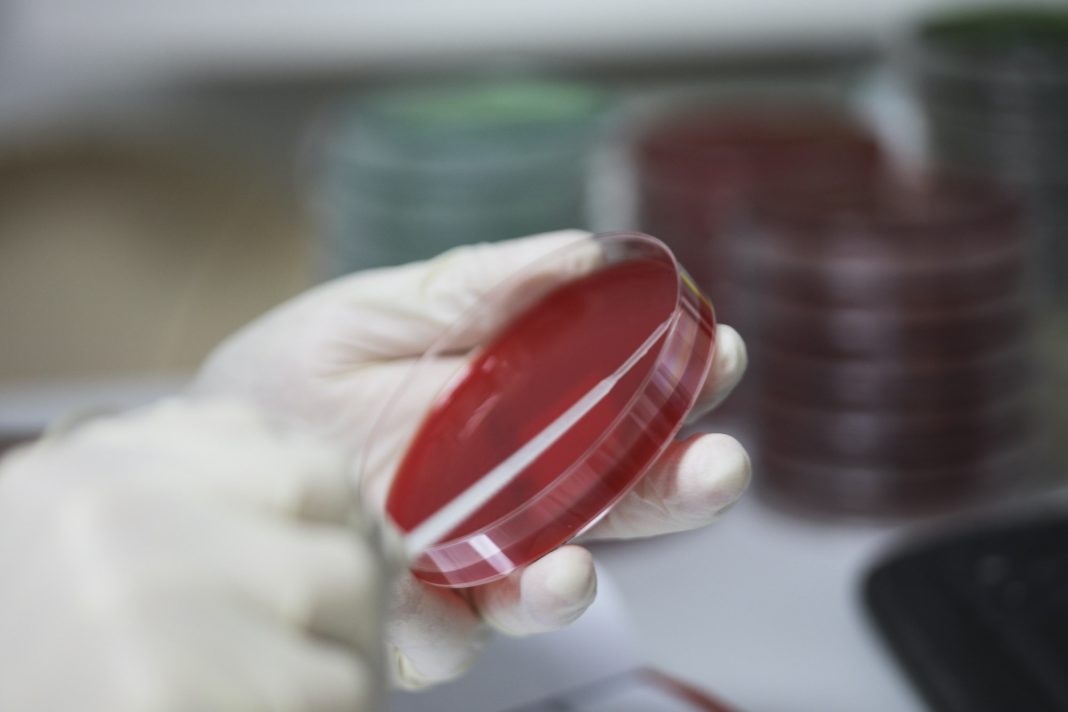
Bărbatul cu botulism internat în Spitalul Judeţean Slatina a murit

Bărbatul din Slatina, confirmat cu botulism pe 14 noiembrie, internat în secția ATI la SJU Slatina, a murit miercuri, în ciuda eforturilor medicilor și a administrării serului antibotulinic înaintea confirmării cazului.
Bărbatul a ajuns la spital pe 7 noiembrie şi a fost internat la Neurologie, după care i s-a agravat starea de sănătate. În ziua următoare a fost transferat la Terapie Intensivă.
„În după amiaza zilei de 12 noiembrie 2022, în serviciile de specialitate ale Spitalului Judeţean de Urgenţă Slatina s-a pus suspiciunea de botulism la un pacient în vârstă de 68 ani, cu domiciliul în mediul urban. Pacientul a fost internat în data de 07.11.2022 în secţia de neurologie, cu diagnosticul: tetrapareză în observaţie etiologică. În data de 8.11.2022, pacientul este transferat în secţia de Terapie Intensivă, prezentând insuficienţă respiratorie acută, se intubează şi după ventilaţie iese din comă”, se arăta într-un comunicat al DSP Olt, conform observatornews.ro.
Un alt bărbat cu suspiciune de botulism a fost internat la Spitalul Judeţean de Urgenţă Slatina
Luni, un alt bărbat, în vârstă de 39 de ani, cu suspiciune de botulism, a fost internat la Spitalul Judeţean de Urgenţă Slatina. I-a fost administrat ser antibotulinic și au fost prelevate probe din alimente consumate de bărbat.
Soţia acestuia a declarat că bărbatul a mâncat, în seara zilei de 13 noiembrie, carne de porc „la garniţă” preparată în decembrie 2021.